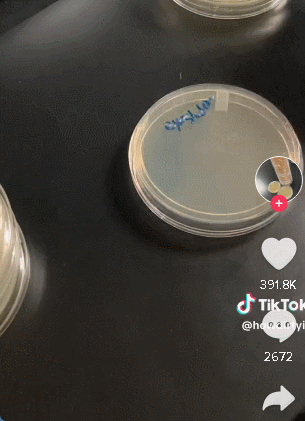
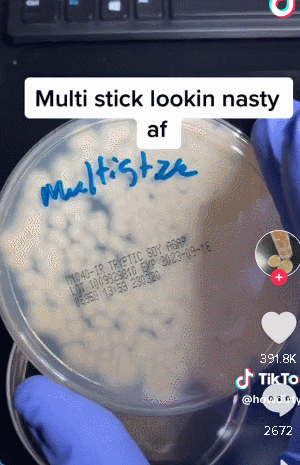
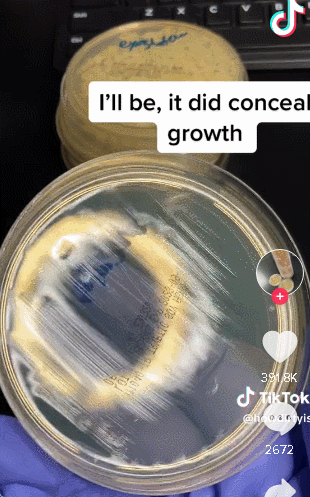

收藏太恶心!测试丝芙兰的试用品到底有多脏!腮红、眼影布满细菌!
最近,一个在TikTok上走红的视频让人们再次考虑是否应该在Sephora试用店内的化妆品。

图源:howdirtyis | TikTok
TikTok用户@howdirtyis发布于4月,标题为:“Sephora的试用品到底有多脏?”的视频,已经获得超过340万次观看。

@howdirtyis进行了一个实验,用棉签擦拭Sephora的口红、腮红、眼影和睫毛膏等店内试用品,检测这些试用品上是否存在细菌。结果令人震惊。

视频中,这位TikToker用棉签擦拭口红、多功能腮红、腮红盘、遮瑕膏、睫毛膏和眼影盘,并将擦拭的样品放入带标签的培养皿中,然后放置一段时间,观察细菌生长。
过了一段时间,TikToker拿起培养皿,发现上面都是细菌。他们首先展示了多功能腮红的培养皿。视频中显示,“多功能腮红完全恶心”,培养皿上几乎完全长满了细菌。
接下来是腮红的培养皿,也几乎被细菌覆盖。眼影盘的培养皿也好不到那里去,上面也有细菌。TikToker说:“各种各样的东西都在这个上面。”

然而,遮瑕膏的培养皿上似乎没有细菌生长,口红和睫毛膏的培养皿也是如此。
这个结果可能让那些曾经在Sephora试用过未经清洁的化妆品感到不安。视频已经获得了超过38.9万个赞和数千条评论,许多人对结果表示震惊。有些人对一些试用品的清洁程度感到惊讶。

一些网友表示,“老实说,口红竟然没有细菌反而让我感到震惊。反而是那些我认为干净的产品竟然是最糟的。”

“遮瑕膏和睫毛膏竟然没有细菌。”另一位网友回复称:“不意外,因为通常大家也只是打开来看看刷头。”

一位作为曾经在Sephora工作过的网友给出了合理的解释,“我们确实更频繁地清洁和更换口红、眼线笔和睫毛膏,而不是粉状产品。”

尤其后疫情时代,现在很少人会在脸上试妆了吧。“还好我只在手背上试用。”

Narcity已联系Sephora以寻求评论,但在截稿前未收到回复。
虽然结果可能看起来很糟,但这位TikToker实际上并没有说明测试样品上存在什么类型的细菌。
然而,在2018年,CBC Marketplace发现大多伦多地区多家美妆店的化妆品测试样品含有金黄色葡萄球菌和霉菌。
Marketplace的制片人秘密调查了Shoppers Drug Mart、Sephora、The Body Shop和MAC Cosmetics等化妆品店,并对60个睫毛膏、唇彩、腮红、口红和眼影的测试样品进行了拭子采样,然后将它们送往微生物学实验室。
根据CBC的报道,实验室发现40%的样品含有金黄色葡萄球菌细菌,28%的样品有霉菌生长。
根据梅奥诊所(Mayo Clinic)的说法,金黄色葡萄球菌细菌可以引起感染,包括皮肤疖和食物中毒。
类似事件发生在2017年Rossen Reports和NBC News' TODAY进行的实验发现,美国知名美妆店(包括Sephora)的化妆品测试样品含有有害细菌,包括大肠杆菌和肺炎克雷伯菌,这两种细菌通常存在于人的肠道中。
如果你经常在Sephora购物,这些信息可能会让你在下次试用测试样品时三思而后行。
本文为转载发布,仅代表原作者或原平台态度,不代表我方观点。澳洲印象仅提供信息发布平台,文章或有适当删改。对转载有异议和删稿要求的原著方,可联络 [email protected]




















你需要登录后才能评论 登录